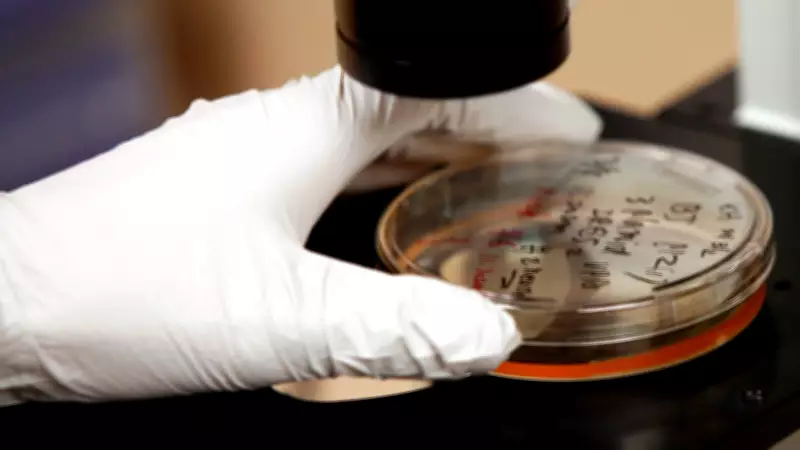
Bactéria estomacal silenciosa pode causar 12 milhões de casos de câncer em uma década

Bactéria estomacal silenciosa pode causar 12 milhões de casos de câncer em uma década
Um estudo recente publicado na renomada revista científica Nature Medicine revelou dados alarmantes sobre os efeitos da Helicobacter pylori, uma bactéria comum encontrada no estômago que, apesar de não apresentar sintomas visíveis em muitos casos, pode desencadear milhões de diagnósticos de câncer ao longo de uma única década.
Impacto devastador da infecção bacteriana
A pesquisa, que examinou detalhadamente os efeitos da Helicobacter pylori, estima que aproximadamente 12 milhões de casos de câncer de estômago podem surgir entre pessoas nascidas ao longo de um período de dez anos. Esta previsão preocupante destaca a necessidade urgente de medidas preventivas e de tratamento para combater a propagação e os danos causados por esta bactéria potencialmente mortal.
Recomendações dos cientistas para redução de riscos
Diante dos resultados alarmantes, os cientistas envolvidos no estudo estão recomendando fortemente o rastreamento imediato e o tratamento precoce de indivíduos infectados com a Helicobacter pylori. De acordo com as projeções da pesquisa, a implementação dessas medidas poderia reduzir o número esperado de casos de câncer de estômago em até 75%, representando uma estratégia crucial para salvar vidas e diminuir a carga sobre os sistemas de saúde.
Entendendo a gravidade da bactéria
A Helicobacter pylori é um tipo de bactéria que infecta o estômago e pode permanecer assintomática por longos períodos, tornando-se uma ameaça silenciosa. No entanto, quando não tratada, ela pode levar a complicações graves, incluindo o desenvolvimento de câncer. As consequências para aqueles que não recebem tratamento adequado são significativas, podendo resultar em diagnósticos tardios e prognósticos desfavoráveis.
Este estudo serve como um alerta importante para a saúde pública, enfatizando a necessidade de maior conscientização sobre os riscos associados a infecções bacterianas comuns e a importância de intervenções médicas oportunas. A comunidade científica continua a investigar formas de melhorar o diagnóstico e o tratamento, visando proteger a população global desta ameaça crescente.









